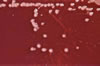

| Psikrotrof |

Psikrotrof |
Psikrotrof |
| Aslen mezofil karakterli olduğu halde psikrofil sınırlarında da gelişebilen, soğuğa dayanıklı, psikrotolerant. Yersinia enterocolitica ve Listeria monocytogenes tipik psikrotrof bakterilerdir. Ayrıca bakınız ; psikrofil, mezofil, termofil, ekstrem termofil, termolabil, termostabil, termodurik |